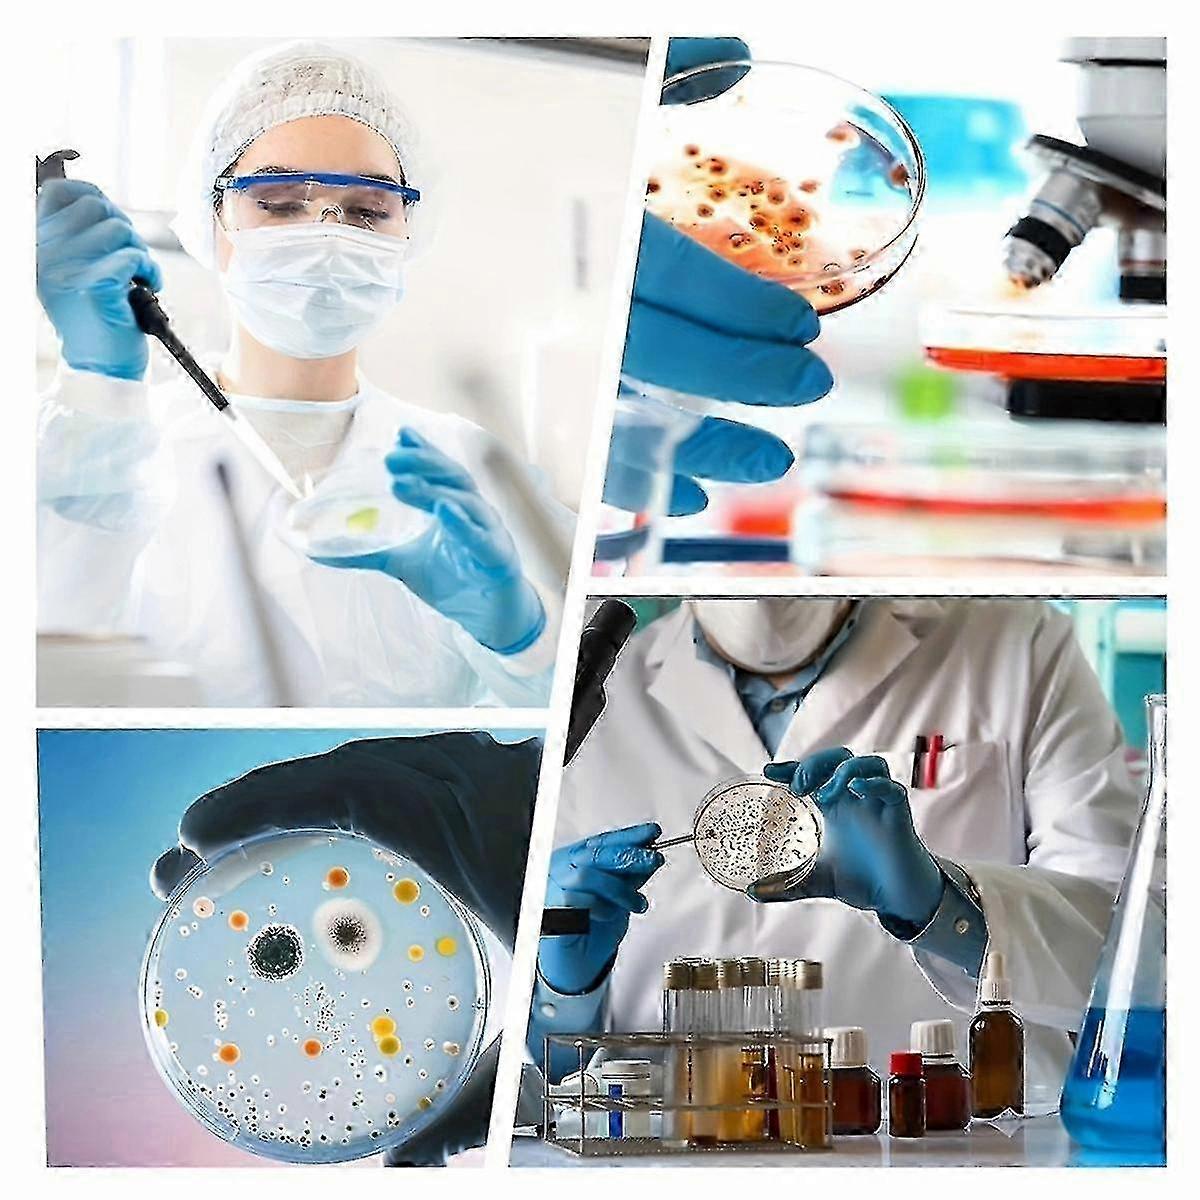

Dish Science Project Kit, Sterile Dish, Dish Cell Observation, Laboratory Bacterial Colony Observation
+ ₱795.99 Shipping
Dish Science Project Kit, Sterile Dish, Dish Cell Observation, Laboratory Bacterial Colony Observation
- Brand: Unbranded
Dish Science Project Kit, Sterile Dish, Dish Cell Observation, Laboratory Bacterial Colony Observation
- Brand: Unbranded
| RRP: | |
| Price: | |
| You save: | ₱140.00 (34%) |
In stock
We accept the following payment methods
Description
- Brand: Unbranded
- Category: Petri Dishes
- Fruugo ID: 329403312-727350967
- EAN: 7672868598987
Product Safety Information
Please see the product safety information specific to this product outlined below
The following information is provided by the independent third-party retailer selling this product.
Product Safety Labels

Delivery & Returns
Dispatched within 24 hours
-
STANDARD: ₱795.99 - Delivery between Mon 10 November 2025–Thu 13 November 2025
Shipping from China.
We do our best to ensure that the products that you order are delivered to you in full and according to your specifications. However, should you receive an incomplete order, or items different from the ones you ordered, or there is some other reason why you are not satisfied with the order, you may return the order, or any products included in the order, and receive a full refund for the items. View full return policy
Product Compliance Details
Please see the compliance information specific to this product outlined below.
The following information is provided by the independent third-party retailer selling this product.
Manufacturer
The following information outlines the contact details for the manufacturer of the relevant product sold on Fruugo.
- Quanzhou Chengxie Trading
- Quanzhouchengxiemaoyiyouxiangongsi
- Shatianyang Development Zone, Haiyou Street, Sanmen County, Taizhou, Zhejiang, China
- Taizhou
- CN
- 317100
- qzchengxie@outlook.com
- 18359021750
- https://www.fruugo.co.uk/quanzhou-chengxie-trading/m-22826
Responsible Person in the EU
The following information outlines the contact information for the responsible person in the EU. The responsible person is the designated economic operator based in the EU who is responsible for the compliance obligations relating to the relevant product sold into the European Union.
- E-CrossStu GmbH
- E-CrossStu GmbH
- 69 Mainzer Landstrasse
- Frankfurt am Main, Hessen
- DE
- 60329
- E-CrossStu@web.de
- +49 69332967674



